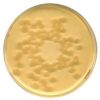

Tryptic Soy Agar – ICR 30ml 20PC Merck
0 ₫
Tryptic Soy Agar – ICR 30ml xuất xứ Merck – Đức, code 1460010020. Hóa chất được sử dụng trong giám sát môi trường cho phòng cách ly & phòng sạch, giám sát không khí chủ động hoặc thụ động, dấu vân tay. Dùng để làm môi trường nuôi cấy để phát hiện nấm & vi khuẩn trong phòng thí nghiệm. Quy cách: 20 tấm/ hộp.
| Tên sản phẩm: | Tryptic Soy Agar – ICR 30ml |
| Tên khác: | TSA, CASO Agar, Casein Soybean Digest Agar, Tryptone Soya Agar |
| Code: | 1460010020 |
| Hãng – xuất xứ: | Merck – Đức |
| Ứng dụng: |
– Hóa chất được sử dụng trong giám sát môi trường cho phòng cách ly & phòng sạch, giám sát không khí chủ động hoặc thụ động, dấu vân tay. – Dùng để làm môi trường nuôi cấy để phát hiện nấm & vi khuẩn trong phòng thí nghiệm. – Là tiêu chuẩn đánh giá và xác định hàm lượng mangan trong dung dịch |
| Tính chất: |
– Hình dạng: rắn, màu be – Giá trị pH: 7,3 (H₂O) |
| Bảo quản: | Bảo quản từ +15°C đến +25°C. |
| Quy cách: | 20 tấm/ hộp |
| Code | Quy cách |
| 1460010020 | 20 tấm/ hộp |
| 1460010120 | 120 tấm/ hộp |
Hãy là người đầu tiên nhận xét “Tryptic Soy Agar – ICR 30ml 20PC Merck” Hủy
Sản phẩm tương tự
Hóa chất thí nghiệm
CAL Check™ chuẩn Clo thang cao, 0.00 và 4.00 mg/L HI96734-11 Hanna
Hóa chất thí nghiệm
CAL Check™ chuẩn Clo tổng, 0.00 và 1.00 mg/L HI96711-11 Hanna
Hóa chất thí nghiệm
Hóa chất thí nghiệm
Hóa chất thí nghiệm
Hóa chất thí nghiệm
CAL Check™ chuẩn Amoni thang trung, 0.0 và 6.0 mg/L HI96715-11 Hanna
Hóa chất thí nghiệm
Dung dịch hiệu chuẩn TDS 12.41 g/L (ppt) HI7036L chai 500ml Hanna
Hóa chất thí nghiệm
CAL Check™ Chuẩn Sắt Thang Thấp, 0.00 và 0.80 mg/L HI96746-11 Hanna

Đánh giá
Chưa có đánh giá nào.